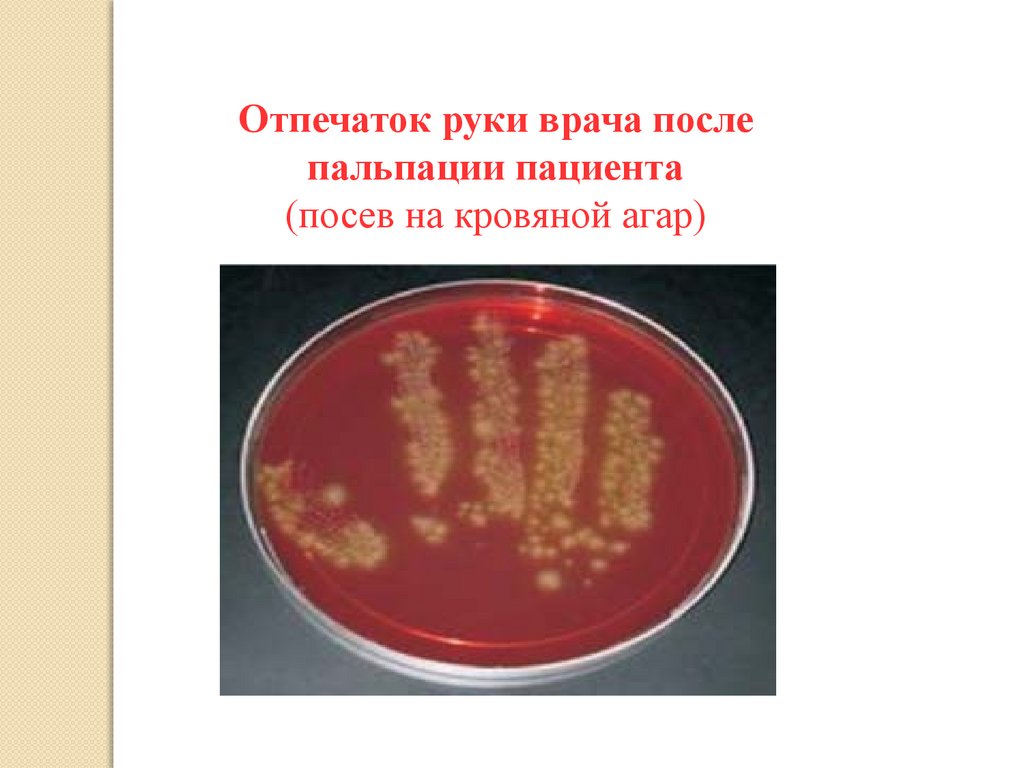

Похожие презентации:
Инфекционный контроль. Профилактика ИСМП
1.
ИНФЕКЦИОННЫЙКОНТРОЛЬ.
ПРОФИЛАКТИКА
ИСМП
2.
План лекционного занятия:1. Пути передачи
2. Основные понятия включающие ИСМП
3. Эпидемический процесс
4. Профилактические мероприятия
3.
Путь передачиБольшинство патогенов могут сохраняться на предметах,
следовательно, они являются неизбежным источником
ИСМП.
Klebsiella spp.
до 30 месяцев
Pseudomonas aeruginosa
до 16 месяцев
Escherichia coli
до 16 месяцев
Staphylococcus aureus, incl. MRSA
до 7 месяцев
Vaccinia virus
до 5 месяцев
Enterococcus spp. incl. VRE + VSE
до 4 месяцев
Adeno virus
HAV
Norovirus
до 3 месяцев
до 2 месяцев
до 7 дней
BODEQUER.PPT/XX,
4.
БЕЗОПАСНАЯ БОЛЬНИЧНАЯ СРЕДАсоздается организацией и проведением
определенных мероприятий
дезинфекц
ия
Режим инфекционной
безопасности
стерилизац
дезинсекц
дератизац
ия
ия
ия
Мероприятия,
обеспечивающие личную
гигиену пациента и персонала
личная гигиена
личная гигиена
пациента
персонала
Лечебно-охранительный
режим
режим
эмоциональной
безопасности
режим дня и
выполнения
процедур
режим
двигательной
активности
5.
ИНФЕКЦИИ, СВЯЗАННЫЕ СОКАЗАНИЕМ МЕДИЦИНСКОЙ ПОМОЩИ
(ИСМП)
ИСМП- Любое клиническираспознаваемое инфекционное
заболевание, возникающее у пациента
или медработника при получении или
оказании медицинской помощивне
зависимости от времени проявления
симптомов во время или после
пребывания в больнице
6.
Виды ИСМП- у пациентов, инфицированных
в стационарах;
- у пациентов, инфицированных
при получении
поликлинической помощи;
- у медицинских работников,
заразившихся при оказании
медицинской помощи больным
в стационарах и поликлиниках.
ЛПУ
7.
Даже в высокоразвитых странах болеечем у 5 - 12% пациентов больницы
возникают ИСПМ
Наиболее распространенные ИСМП:
1. Гнойно-септические инфекции
системы
2. Инфекции мочевыделительной
3. Инфекции дыхательного тракта
4. Бактериемии
5. Кожные инфекции
8.
9.
ИНФЕКЦИИ, СВЯЗАННЫЕ СОКАЗАНИЕМ МЕДИЦИНСКОЙ
ПОМОЩИ
Присоединение ИСМП к основному
заболеванию:
сводит на нет результаты операций на
жизненно важных органах
увеличивает
послеоперационную
летальность
сводит на нет усилия, затраченные на
выхаживание новорожденных
влияет на детскую смертность
увеличивает длительность пребывания в
стационаре
10.
ИНФЕКЦИИ, СВЯЗАННЫЕ СОКАЗАНИЕМ МЕДИЦИНСКОЙ
ПОМОЩИ
ИСМП характеризуют:
высокая контагиозность
((заразительность) – способность
передаваться от больного
здоровому, отличает
инфекционные заболевания от
других)
возможность вспышек в любое
время года
наличие пациентов с
повышенным риском заболевания
возможность рецидивов
широкий спектр возбудителей
11.
ВОЗБУДИТЕЛИ ИСМПБактерии
Вирусы
Staphylococus
spp.,
Streptococcus
spp.,
Enterococus spp., Psevdomonas spp., Escherichia
spp.,
Klebsiella
spp.,
Enterobacter
spp.,
Acinetobacter spp., Serratia spp., Proteus spp.,
Citrobacter spp., Clostridium spp., Mycobacterium
spp., Salmonella spp., Shigella spp., Yersinia spp.,
Legionella spp. и др.
ВИЧ, вирусы гепатита В,С,Д, ротовирусы,
норовирусы, энтеровирусы, вирусы гриппа и
других ОРВИ, кори, краснухи, эпидемического
паротита, герпеса, цитомегаловирусы,
коронавирусы (SARS –CoV) и др.
Candida albicans, Aspergilius spp.
Грибы
Cryptosporidium spp, Pheymocystis carinii
12.
Структура ИСМПВсе микроорганизмы делятся на:
непатогенные – никогда
инфекционного процесса
не
вызывающие
условно-патогенные – вызывающие развитие
инфекционного процесса только при определенных
условиях
патогенные
заболевания
–
способные
вызывать
Патогенность (болезнетворность) – видовой
признак
микроорганизма,
закрепленный
генетически и характеризующий способность
вызывать заболевание
13.
вирулентность– степень, мера патогенности,
индивидуально присущая конкретному штамму
патогенного возбудителя (штамм – это чистая
одновидовая
культура
микроорганизмов,
выделенная
из
определенного
источника
и
обладающая специфическими физиологическими и
биохимическими признаками)
токсигенность – способность к выработке и
выделению
различных
токсинов
(экзои
эндотоксинов)
инвазивность (агрессивность) – способность к
проникновению в ткани и органы макроорганизма и
распространению в них
14.
Если брать за основу возбудителейзаболеваний
все ИСМП можно разделить на две группы:
1 группа – вызывается патогенными
микроорганизмами
(15-20
%
всех
случаев)
2
группа
–
вызывается
условнопатогенными
микроорганизмами
и
занимает ведущее место в структуре
ИСМП крупных многопрофильных ЛПМО
15.
ПАТОГЕННЫЕУСЛОВНО-ПАТОГЕННЫЕ
кишечная палочка,
детские инфекции,
синегнойная палочка,
кишечные инфекции –
клебсиэлла, протей,
сальмонеллез, шигеллез
энтеробактерии,
(дизентерия) и гепатиты
стафилококки,
стрептококки и пр.
вызывают гнойно-
при заносе патогенных
микроорганизмов в ЛПМО
возникают единичные
или множественные
септические заболевания
формируют
госпитальный штамм с
высокой устойчивостью к
антибактериальным
Госпитальный штамм микроорганизма
– это адаптированный к
случаи инфекционных
конкретным условиям конкретного
стационара возбудитель,
препаратам,
заболеваний,
способный
вызвать заболевание у больных, находящихся на
дезинфектантам,
лечении в этом стационаре
16.
Как и любое инфекционное заболевание,ИСМП развивается по определенным
законам инфекционного процесса
Инфекционный процесс
–
это
сложный
процесс
взаимодействия
возбудителя и макроорганизма в определенных
условиях
внешней
и
внутренней
среды,
включающий
развивающиеся
патологические
защитно-приспособительные и компенсаторные
реакции
Инфекционная
болезнь
– это клинически
проявляющаяся
форма
инфекционного
процесса
Носительство
– бессимптомная форма
инфекционного процесса,
протекающая
на
субклиническом уровне
17.
ФАКТОРЫ, ПОВЫШАЮЩИЕВОСПРИИМЧИВОСТЬ ЧЕЛОВЕКА
В ИСМП:
Возраст (детский/пожилой);
Питание;
Наличие хронических заболеваний;
Наличие ран и свежих
послеоперационных швов;
Часто проводимые инвазионные
процедуры.
18.
ТИПИЧНЫЕ МЕСТАОБИТАНИЯ ИСМП
воздух; 5%
пациент; 50%
Основные факторы передачи
РУКИ!
Белье
воздух
Оборудование
инструменты
Инструментарий
персонал
Инъекционные растворы пациент
Воздух
инструменты;
10%
персонал; 35%
19.
Перенос микроорганизмов с контаминированнойповерхности на руки
Помещение
Вид контакта
Уровень
трансмиссии
Одноместная палата
Контакт без касания пациента
42%
Палата в обычном
отделении
Контакт с перилами кровати и
столиком в течение 5 секунд
46%
ОРИТ
Контакт с близким окружением
пациента во время ухода
52%
Лаборатория
Контакт с
контаминированными
объектами
40%
20.
Факторы, способствующиеувеличению распостранения
ИСМП
-Недооценка эпидемической опасноти
внутрибольничных источников инфекции и
риска заражения при контакте с пациентом;
- перегрузка ЛПУ;
-наличие невыявленных носителей
-
внутрибольничных штаммов среди
медперсонала и пациентов;
21.
- нарушение медперсоналом правиласептики и антисептики, личной
гигиены;
-несвоевременное проведение текущей и
заключительной дезинфекции, нарушение
режима уборки;
22.
- недостаточное оснащение ЛПУ дезинфекционнымисредствами;
- нарушение режима дезинфекции и стерилизации
медицинских инструментов, аппаратов, приборов и т. д.;
- устаревшее оборудование;
- неудовлетворительное состояние пищеблоков,
водоснабжения;
- отсутствие фильтрационной вентиляции.
23.
РАСПРОСТРАНЕНИЮ ИСМП ВЛПУ СПОСОБСТВУЮТ:
Создание крупных больничных
комплексов;
Манипуляции и их характер;
Длительность пребывания
пациента в стационаре;
Использование аппаратуры,
требующей особой обработки.
24.
ЭПИДЕМИЧЕСКИЙ ПРОЦЕССЭто
процесс возникновения и
распространения инфекционных
состояний (в виде болезней и
носительства)
Для
возникновения
эпидемического
процесса
необходимо
наличие
трех
факторов (звеньев)
возбудите
ль
передача
Цепочка инфекции
человек
25.
ИСТОЧНИК ИНФЕКЦИИИсточниками ИСМП могут быть
пациенты, медицинский персонал,
студенты, посетители, родственники
пациентов, технические работники
Источники
во
внешней
среде:
аппаратура, стены, инструменты,
перевязочный материал….
26.
ЦЕПОЧКА ИНФЕКЦИОННОГОПРОЦЕССА
Возбудитель болезни
Способ передачи
Резервуар
Входные ворота
инфекции
Выходные ворота
инфекции
Восприимчивый
хозяин
27.
Пути распространения ВБИЭкзогенные
инфекции
Перенос инфекции
извне
Эндогенные инфекции –
ИНФЕКЦИОННЫЙ АГЕНТ
ПРИСУТСТВУЕТ В
ОРГАНИЗМЕ
ИЗНАЧАЛЬНО
1.Аэрозольный
1. Гемотагенный
2.Контактный
2. Лимфогенный
3.Фекально-
3. Контактный
оральный
4.Артифициальный
28.
СПОСОБЫ ПЕРЕДАЧИИНФЕКЦИИ:
СПОСОБ
ПЕРЕДАЧИ
КОНТАКТНЫЙ
-Прямой;
-Непрямой
ФЕКАЛЬНООРАЛЬНЫЙ
-Контактнобытовой;
-Водный;
-Пищевой
АЭРОЗОЛЬНЫЙ ВЕРТИКАЛЬНЫЙ
-Воздушно-Трансплаценкапельный;
тарно
-Воздушнопылевой
ТРАНСМИС
СИВНО
- Через укус
29.
Механизмы и пути передачиИСМП
Механизм
Пути
Факторы,
Заболеван
передач способствующие
ия
и
распространению
Кондиционеры,
не
содержащие
бактериальные
фильтры, по единой
Все
вентиляционной
заболевания
системе
Воздушнодыхательны
Вдыхание
Аэрогенный капельный
х путей:
инфицированного
грипп, ОРВИ,
(аэрозольны
воздуха
при
Воздушнотуберкулез
й)
отсутствии
пылевой
респираторных
Раневая
средств защиты у
инфекция
медперсонала
30.
МеханизмПути
передачи
Факторы,
способствующие
распространению
Руки медперсонала
пациентов
Заболевания
и
Острые
Белье, посуда, предметы
Контактнокишечные
ухода
бытовой
инфекции
(предметно(пищевые
бытовой)
Прием
пищи токсикоФекальноприготовленной:
инфекции,
с
нарушением
оральный Алиментарно дизентерия,
санитарных норм
-пищевой
сотрудником сальмонеллез
пищеблока, носителем )
Водный
инфекции
Водная среда при выходе
из строя канализационной
системы
Гепатит А
31.
МеханизмПути
передачи
Контактнобытовой
прямой
Факторы,
способствующие Заболевания
распространению
Непосредственный
контакт
ИППП
Промежуточный контакт
–
ГнойноКонтактночерез
руки, воспалительные
инструменты,
Контактный бытовой
заболевания
перевязочный материал,
косвенный
аппаратуру
Малярия
Сыпной
тиф
Трансмиссивный
Крымская
Живой
переносчик, геморрагическа
обычно кровососущее я лихорадка
насекомое
32.
МеханизмПути передачи
Факторы,
способствую Заболеван
щие
ия
распростране
нию
Артифициальный При
Гемоконтактный
выполнении
парентеральный (искусственный
инвазивных
медицинский)
процедур
ВИЧ
гепатит В и
С сифилис
33.
ИНФЕКЦИОННЫЙ КОНТРОЛЬопределяется
как
система
эффективных организационных,
профилактических
и
противоэпидемических
мероприятий, направленных на
предупреждение возникновения
и распространения госпитальных
инфекций,
базирующаяся
на
результатах эпидемиологической
диагностики
Цель
–
снижение
заболеваемости, летальности и
экономического
ущерба
от
госпитальных инфекций
34.
СИСТЕМА ИНФЕКЦИОННОГОКОНТРОЛЯ
1.
Структура
управления
и
распределения
обязанностей
по
инфекционному контролю
создание
комитета
инфекционного
контроля,
который
решает
вопросы
распределения обязанностей и обеспечения
мероприятий по инфекционному контролю,
согласовывает проводимые мероприятия с
администрацией ЛПМО и координирует их
2. Система учета и регистрации ИСМП
Наличие в стационаре системы активного
выявления госпитальных инфекций
35.
СИСТЕМА ИНФЕКЦИОННОГОКОНТРОЛЯ
3.
Микробиологическое
обеспечение
инфекционного контроля
по
результатам
исследований
специалисты анализируют и оценивают
чувствительность
выделенных
штаммов
микроорганизмов
к
антибиотикам, дезинфектантам,
антисептикам и физическим факторам
воздействия.
создание
базы
данных
штаммов,
полученных
в
микробиологической
лаборатории, обеспечивает проведение
полноценного
эпидемиологического
анализа
36.
СИСТЕМА ИНФЕКЦИОННОГОКОНТРОЛЯ
4. Эпидемиологический анализ ИСМП
эпидемиологический анализ проводится в
соответствии с четко сформулированными
целями и задачами, исходя из потребностей и
особенностей ЛПМО
5. Профилактические и противоэпидемические
мероприятия
в
системе
инфекционного
контроля
разработка инструкций, указаний, алгоритмов
эпидемически безопасных диагностических и
лечебных процедур
проведение
эффективных
процедур
стерилизации, дезинфекции и обработки рук
персонала
37.
СИСТЕМА ИНФЕКЦИОННОГОКОНТРОЛЯ
6. Обучение персонала
разработка
программ
для
обучения
специалистов
разного
профиля
по
проблемам инфекционного контроля с
учетом специфических особенностей ЛПМО
обучение персонала при приеме на работу
и в дальнейшем регулярно
38.
СИСТЕМА ИНФЕКЦИОННОГОКОНТРОЛЯ
7. Охрана здоровья персонала
выявление и оценка профессиональных
факторов риска в данном ЛПМО
подготовка
и анализ соответствующей
информации
разработка
и
внедрение
программ
профилактики
профессиональной
заболеваемости
39.
СИСТЕМА ИНФЕКЦИОННОГОКОНТРОЛЯ
8. Охрана здоровья пациентов
выполнение медицинской сестрой
требований
санитарнопротивоэпидемического режима:
соблюдения чистоты самого
пациента,
белья,
посуды,
предметов личной гигиены,
предметов ухода, помещения
предотвращения
распространения инфекции
40.
Нормативно-правовые документыНормативно-правовые документы, регламентирующие
профилактику ИСМП, организационно-методические документы
по инфекционному контролю и инфекционной безопасности:
Федеральный закон №323-ФЗ «Об основах охраны здоровья
граждан в Российской Федерации»
Федеральный закон от 30.03.1999г. №52-ФЗ «О санитарноэпидемиологическом благополучии населения». с редакцией от
01.07.2025
Постановление Главного государственного санитарного врача РФ
от 28 января 2021 г. N 4 "Об утверждении санитарных правил и
норм
СанПиН
3.3686-21
"Санитарно-эпидемиологические
требования по профилактике инфекционных болезней"
Министерство труда и социальной защиты Российской федерации
приказ ОТ 18 ДЕКАБРЯ 2020 Г. n 928Н об утверждении правил по
охране труда в медицинских организациях.
Постановление
от 24.12.2020 №44 ОБ УТВЕРЖДЕНИИ
САНИТАРНЫХ ПРАВИЛ СП 2.1.3678-20
41.
ВОСПРИИМЧИВОСТЬ ЧЕЛОВЕКАК ИНФЕКЦИИ
Восприимчивость
– биологическое свойство организма,
тканей человека или животного быть оптимальной средой
для размножения возбудителя (это свойство обусловлено
генетически)
Факторы, влияющие на восприимчивость человека к
инфекции:
возраст, питание, наличие сопутствующих заболеваний
наследственность, иммунизация
приобретенный иммунодефицит
психологическое состояние
любое нарушение целостности кожных покровов и
слизистых
хирургическое вмешательство
курение
лекарственная терапия
42.
Универсальные меры безопасностимедицинского персонала от инфекции
Всех пациентов необходимо
рассматривать как потенциально
инфицированных ВИЧ и другими
передаваемыми с кровью
инфекциями
Медицинскому персоналу следует
помнить и применять
7 правил безопасности
для защиты кожи и слизистых оболочек при
контакте с кровью или жидкими
выделениями организма любого пациента
43.
Мытьруки до и после любого контакта с
пациентом
Рассматривать кровь и жидкие выделения всех
пациентов как потенциально инфицированные
и работать с ними только в перчатках
Сразу
после
применения
помещать
использованные шприцы и катетеры в
специальный контейнер для дезинфекции
острых предметов, никогда не снимать со
шприцов иглодержатели с иглами и не
производить
никаких
манипуляций
с
использованными
иглами.
Необходимо
избегать
надевания
колпачков
на
использованные иглы
44.
Пользоватьсясредствами защиты
глаз
и
масками
для
предотвращения
возможного
попадания брызг крови или
жидких выделений в лицо (во
время хирургических операций,
манипуляций, катетеризаций и
лечебных процедур в полости рта)
Использовать специальную влагонепроницаемую
одежду
для
защиты тела от возможного
попадания брызг крови или
жидких выделений
45.
Рассматриватьвсе
белье,
запачканное
кровью
или
жидкими выделениями, как
потенциально инфицированное
Рассматривать
все
образцы
лабораторных анализов как
потенциально инфицированные
Осуществлять транспортировку
БЖ только !!!! В закрытых
контейнерах
46.
Роль медперсонала впрофилактике ИСМП –
главенствующая роль!
47.
Аварийная ситуация- попадание крови илидругих биологических жидкостей пациента на
кожу, слизистые медработника, а также при
травматизации при выполнении медицинских
манипуляций.
48.
49.
Действия медицинского работника приаварийной ситуации в соответствии с
Постановление Главного государственного
санитарного врача РФ от 28 января 2021 г. N 4
"Об утверждении санитарных правил и норм
СанПиН 3.3686-21 "Санитарноэпидемиологические требования по
профилактике инфекционных болезней"
50.
В случае порезов и уколовнемедленно снять перчатки
промыть руки с мылом под
проточной водой
обработать руки 70% спиртом
смазать рану 5% йодом
При попадании биологической
жидкости на кожные покровы
место обрабатывают 70% спиртом
повторно обрабатывают спиртом
моют под проточной водой
51.
При попадании крови и другихбиологических жидкостей
пациента на слизистую глаз, носа
и рта
ротовую полость промыть большим
количеством воды
прополоскать 70% раствором
этилового спирта
слизистую оболочку носа и глаза
обильно промывают водой (не тереть)
При попадании крови и других
биологических жидкостей пациента на
халат, одежду
снять рабочую одежду и погрузить в
дезинфицирующий раствор или в бикс
(бак) для автоклавирования
52.
АПТЕЧКА «АНТИВИЧ»Аптечка АнтиВИЧ предназначена
для оказания первой помощи и
профилактике
распространения
ВИЧ-инфекции
на
предприятиях
быта.
53.
Домашнее задание:1. Изучить аварийные ситуации попадание
биологической жидкости на кожу, слизистые
одежду2.1.3678-20 "САНИТАРНОЭПИДЕМИОЛОГИЧЕСКИЕ ТРЕБОВАНИЯ К
ЭКСПЛУАТАЦИИ ПОМЕЩЕНИЙ, ЗДАНИЙ,
СООРУЖЕНИЙ, ОБОРУДОВАНИЯ И
ТРАНСПОРТА, А ТАКЖЕ УСЛОВИЯМ
ДЕЯТЕЛЬНОСТИ ХОЗЯЙСТВУЮЩИХ
СУБЪЕКТОВ, ОСУЩЕСТВЛЯЮЩИХ ПРОДАЖУ
ТОВАРОВ, ВЫПОЛНЕНИЕ РАБОТ ИЛИ
ОКАЗАНИЕ УСЛУГ"
54.
Тема: Инфекционнаябезопасность на рабочем
месте
55.
56.
Известно, что на коже рук всегда в том илиином количестве присутствует
микрофлора , т.е микроорганизмы.
1 см2 кожи 100
- 1000
бактерий
57.
Роль основоположникаобработки рук отводится
венгерскому акушеру Игнацу
Филиппу Земмельвайсу
(Semmelweis) (1818-1865),
который в 1846 году установил
причину послеродового сепсиса и
предложил метод обработки рук
акушерок хлорной водой.
1847 - после введения адекватной обработки рук
медицинского персонала, уровень смертности от
послеродовых стрептококковых инфекций удалось
снизить в 7!!!!! раз
58.
I. Резидентная (нормальная) микрофлора – этомикроорганизмы, постоянно живущие и
размножающиеся на коже.
II.
Транзиторная
микрофлора
–
это
неколонизирующая
микрофлора,
приобретённая медицинским персоналом в
процессе работы в результате контакта с
инфицированными объектами окружающей
среды.
59.
• стимулирует образование антител и препятствуетзаселению
кожи
грамотрицательными
микроорганизмами. Обитает в роговом слое кожи,
находится в волосяных фолликулах, сальных, потовых
железах, в области ногтевых валиков, под ногтями,
между пальцами.
• преимущественно
представлена
кокками:
эпидермальным и другими видами стафилококков,
дифтероидами, пропионибактериями.
• ее невозможно полностью удалить при обычном мытье
рук и обработке антисептиками.
60.
• Представленапреимущественно
микроорганизмами,
находящимися во внешней среде учреждения, опасными в
эпидемиологическом отношении:
- патогенные микроорганизмы (сальмонеллы,
вирусы
гепатита А и др.);
- условно-патогенные микроорганизмы:
грамположительные (стафилококки золотистый и
эпидермальный);
грамотрицательные (кишечная палочка, клебсиеллы,
псевдомонады);
грибы (кандиды, аспиргиллы).
• Сохраняется на руках не более 24 часов и может быть
удалена путем обычного мытья рук и обработки
антисептиками.
61.
Отпечаток руки врача послепальпации пациента
(посев на кровяной агар)
62.
ЗАПОМНИТЕ!МЫТЬЕ РУК – важнейшая процедура,
позволяющая предупредить ИСМП
Выделяют три уровня деконтаминации
рук:
СОЦИАЛЬНЫЙ
ХИРУРГИЧЕС
КИЙ
ГИГИЕНИЧЕС
КИЙ
63.
Уровнидеконтаминации рук
способ
обработки
цель обработки
(степень деконтаминации)
гигиеническая
обработка рук
удаление загрязнений,
удаление /уничтожение
транзиторной микрофлоры
хирургическая
обработка рук
удаление/уничтожение
транзиторной микрофлоры и
снижение численности
резидентной флоры
64.
65.
66.
В 2006 г. в Женеве ВОЗ приняларезолюцию «всемирный альянс
за безопасность пациента».
Ключевая акция :
« Руководство ВОЗ по гигиене рук в
здравоохранении».
«Золотой» стандарт – спиртовой
антисептик
67.
Важно иметь ввиду, чтоспиртосодержащие средства для
дезинфекции надо применять на
абсолютно сухие руки
68.
69.
Виды кожных реакций• Контактный дерматит –
сухость,раздражение, потрескавшаяся
кожа, кровоточивость
• Аллергический контактный дерматит –
в основном, к ингредиентам состава
рецептур.
70.
Причины дерматитовИспользование горячей воды
Качество бумажных полотенец
Неполное высушивание рук
Недостаток применения кремов и
лосьонов
71.
Мероприятия, снижающиевероятность развития дерматита
тщательное ополаскивание и
высушивание рук;
использование адекватного количества
антисептика (избегать излишков);
использование современных и
разнообразных антисептиков;
обязательное использование
увлажняющих и смягчающих кремов
72.
Мероприятия по профилактике ИСМП в ЛПУ:Строгое соблюдение действующих
директивных документов по профилактике
ИСМП.
Максимальное использование одноразового
инструментария и одноразовых перчаток.
Отказ от применения многоразового
инструментария.
Соблюдение технологии мытья рук
Индивидуальная изоляция (работать с
каждым пациентом без применения общего
стерильного стола, с использованием только
индивидуальных укладок, исключением
общего расходного материала).
Соблюдение правил личной гигиены и
санитарные нормы при уходе за больными.
Соблюдать алгоритмы выполнения
манипуляций.
73.
Соблюдать режимы обработки инструментария.Применят в работе бактерицидные облучатели.
Определять косвенные признаки ИСМП при
проведении перевязок, манипуляций; сообщать
при выявлении таковых лечащему врачу.
Активное выявление инфекционных пациентов
(подозрение на кишечную инфекцию, брюшной
тиф, дифтерию, вирусный гепатит).
Соблюдение правил сбора, хранения и удаления
отходов в ЛПУ, согласно постановлениям и
Сан.Пин
Контроль состояния здоровья медперсонала
(предварительные, периодические и
профилактические медосмотры, обязательная
иммунизация персонала).
Повышение квалификации медперсонала
(персонал обязан знать клиническую картину
инфекционных болезней, источники, пути их
распространения).
74.
Применение защитных перчатокПерчатки необходимо надевать во
всех случаях, когда возможен
контакт:
- с поврежденной кожей и
слизистыми оболочками;
-биологическими жидкостями
(кровь, моча, рвотные массы
итд)потенциально или явно
контаминированными
микроорганизмами;
-при работе в агрессивных средах
75.
Применение перчатокПрименение перчаток не
самостоятельная , а
дополнительная мера для
защиты рук медицинского
персонала
76.
Применение стерильныхперчаток
Использование
стерильных перчаток –
для проведения любых
асептических
(стерильных) процедур,
кроме
в/м, в/в инъекций, забора
венозной крови, установки
периферического катетера
77.
Применение перчатокПрименение перчаток само по
себе может оказывать
негативное воздействие на
кожу
перчатки «закупоривают» поры
кожи, что приводит к перегреву и
потению рук и вызывает
мацерацию эпидермиса
Важно! Никогда не надевайте
перчатки на влажные руки!!!
78.
Применение перчатокРуки в перчатках подвергаются
такой же опасности передачи
вирусов, как руки без перчаток
Никогда не используйте одни и
те же перчатки при уходе более
чем за одним пациентом
При переходе от загрязненной
к чистой поверхности тела
пациента необходимо сменить
перчатки
79.
Применение перчатокИспользование перчаток не
отменяет дезинфекции рук!
в перчатках могут возникнуть
микропроколы,
предоставляющие возможность
патогенам проникнуть под них
снятие перчаток несет в себе
существенный риск заражения
рук патогенами с внешней
поверхности перчаток
80.
Показания для гигиены рукКаждый раз перед
надеванием и снятием
перчаток нужна
гигиеническая обработка
рук методом втирания
спиртосодержащих
антисептиков
81.
Все медработники,деятельность которых
предполагает контакт с
кровью, должны надевать
перчатки:
Стерильные перчатки - при
контакте со стерильными тканями.
Чистые перчатки - при контакте со
слизистыми оболочками или
неповрежденной кожей пациента.
Хозяйственные перчатки - для
мытья загрязненного
инструментария и стеклянного
оборудования.
82.
ЗАЩИТНАЯ ОДЕЖДАМАСКИ
обеспечивают минимальную защиту от
микроорганизмов, передающихся воздушно-капельным
путем. Маску все равно следует надевать, но носить
непрерывно можно не более 2 ч.
ОБУВЬ И МЕДИЦИНСКИЕ ШАПОЧКИ не
защищают от инфекции.
ЗАЩИТНЫЕ ОЧКИ
могут защитить глаза, нос,
рот от попадания в них крови и другой биологической
жидкости.
Пользуясь
защитной
одеждой,
важно
правильно снять ее, чтобы не загрязнить
свои руки, одежду и окружающие предметы!
83.
юр
а
д
о
г
а
л
Б
!
е
и
н
а
м
и
н
в
за

Медицина
Медицина








